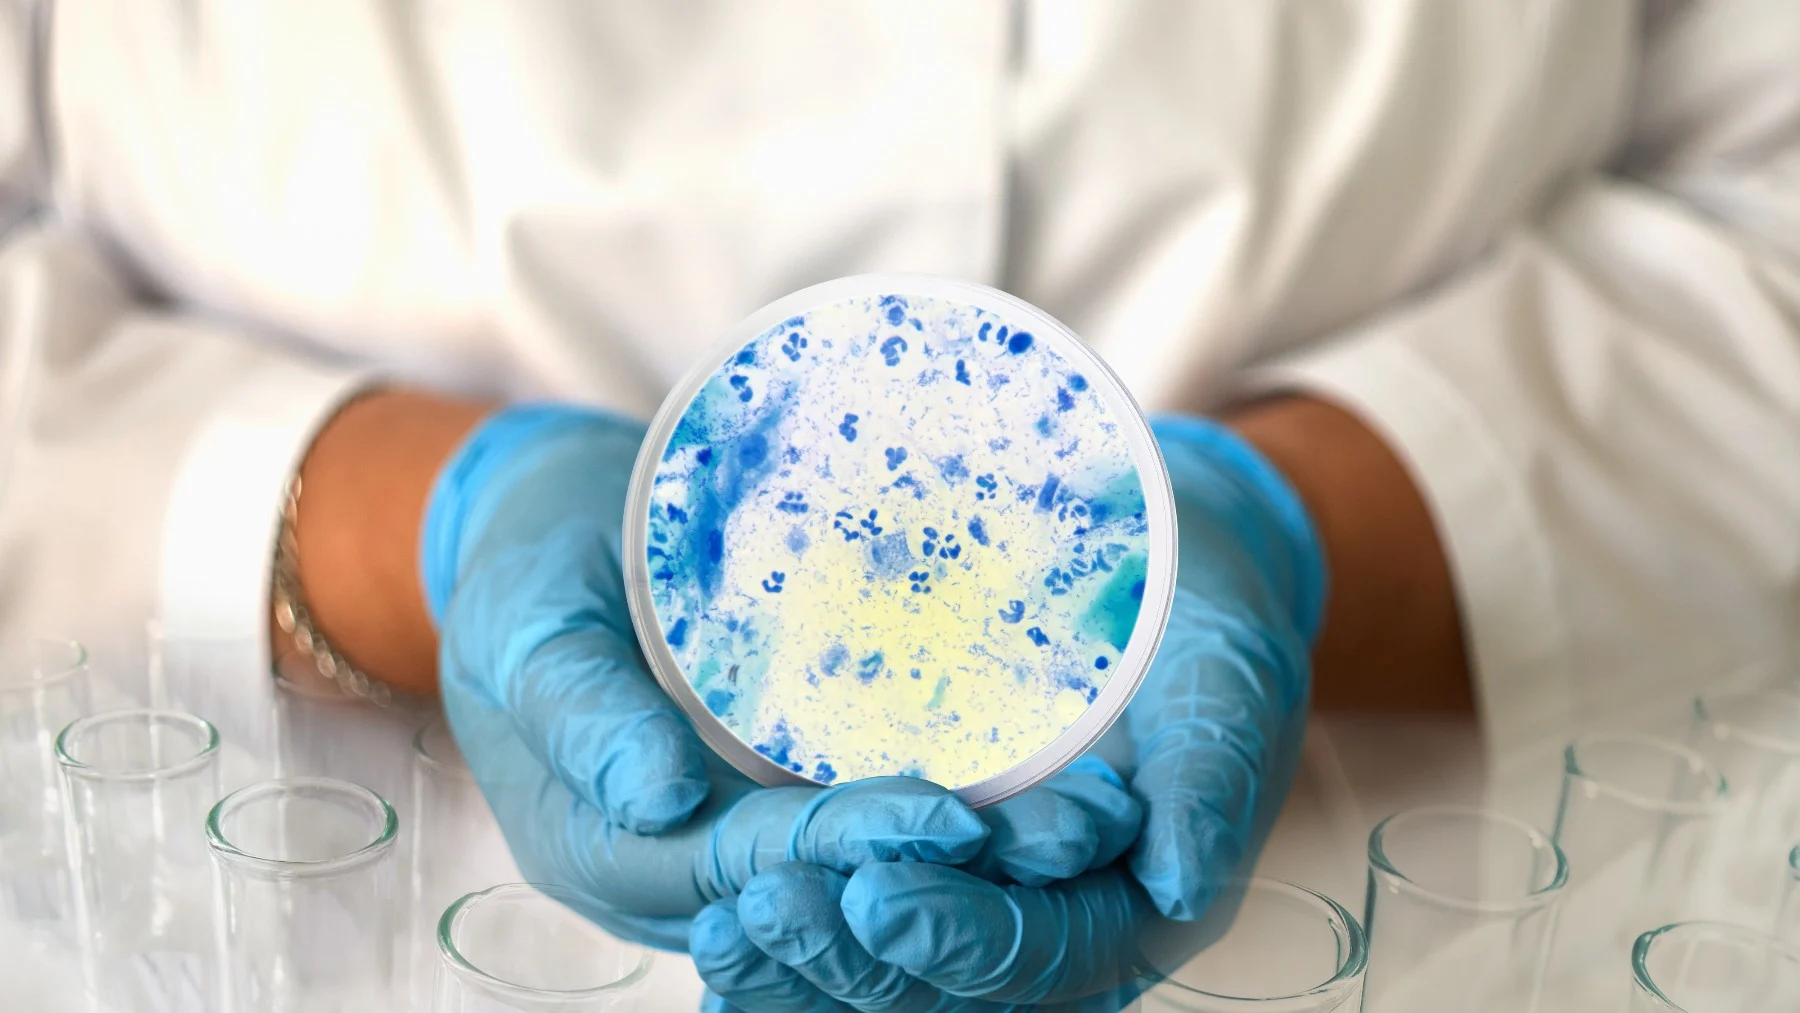

# Trichomoniasis Test vs Other STI Tests: What Makes It Different?
Sexually transmitted infection screening is an essential part of maintaining sexual health, but not all tests work the same way. A Trichomoniasis test differs from other STI tests in how the infection behaves, how it is detected, and why it is often overlooked. Understanding these differences helps individuals make informed decisions about testing and prevention.
# Why Trichomoniasis Requires Specific Testing?
**[Trichomoniasis Test in Dubai](https://stdtestdubaiuae.ae/services/trichomoniasis-test-in-dubai/)** is caused by the parasite Trichomonas vaginalis, which sets it apart from bacterial and viral STIs. Unlike infections such as chlamydia or gonorrhea, trichomoniasis is parasitic and may not always be included in standard STI screening panels.
Because symptoms are often mild or absent, many people assume they are not infected. A Trichomoniasis test is designed specifically to detect this parasite, making it a critical tool for accurate diagnosis that general STI tests may miss.
# How Trichomoniasis Differs From Common STIs?
Many sexually transmitted infections share overlapping symptoms, such as genital irritation or discharge. However, trichomoniasis often presents inconsistently. Some individuals experience noticeable discomfort, while others remain asymptomatic for long periods.
This unpredictability makes targeted testing important. While other STI tests focus on bacterial cultures or viral antibodies, Trichomoniasis testing identifies the presence of a living parasite. This difference affects how samples are collected and how results are interpreted.
# Comparing Diagnostic Methods Across STI Tests:
STI tests vary based on the type of infection being detected. Bacterial infections are often identified through nucleic acid tests or cultures, while viral infections may require blood tests to detect antibodies or viral load.
A Trichomoniasis test typically uses advanced laboratory techniques to detect the genetic material of the parasite. These methods are highly sensitive and can identify infection even when symptoms are absent. In contrast, some STI tests rely on visible signs or immune response, which may take longer to develop.
# Sample Collection: What Makes Trichomoniasis Testing Unique
Sample collection for a Trichomoniasis test may involve vaginal swabs, urethral swabs, or urine samples. The choice depends on the individual and testing method. This approach is similar to some bacterial STI tests but differs from blood-based testing used for viral infections.
Because the parasite lives in the genital tract, direct sampling from the affected area improves accuracy. Proper sample collection plays a major role in reliable results, making clinical guidance especially important.
# Accuracy and Detection Windows Compared:
Detection windows vary across STI tests. Some infections can be detected shortly after exposure, while others require more time before they are identifiable. Trichomoniasis testing requires an appropriate window to ensure the parasite is present in detectable levels.
Compared to antibody-based tests for viral STIs, Trichomoniasis tests often provide earlier confirmation once the infection is established. Understanding these timing differences helps reduce false results and unnecessary repeat testing.
# Why Trichomoniasis Is Often Missed in Routine Screening?
One key difference between a Trichomoniasis test and other STI tests is its exclusion from many routine screening panels. This means individuals may test negative for common STIs while still carrying trichomoniasis.
Healthcare providers may recommend specific testing based on symptoms, sexual history, or partner diagnosis. Advocating for comprehensive screening ensures that less commonly tested infections are not overlooked.
# Interpreting Results Across Different STI Tests:
A positive Trichomoniasis test indicates an active parasitic infection that requires treatment. This differs from some viral STI tests, where a positive result may indicate past exposure rather than current infection.
Negative results across STI tests should be interpreted in context. Ongoing risk factors or new exposures may require future testing. Understanding what each test detects helps individuals better understand their sexual health status.
# The Role of Targeted Testing in Prevention:
Targeted testing plays a major role in preventing the spread of trichomoniasis. Because reinfection is common, accurate diagnosis and partner testing are essential. This approach differs from some STI prevention strategies that focus primarily on long-term management rather than complete clearance.
Including a **[Trichomoniasis test](https://stdtestdubaiuae.ae/services/trichomoniasis-test-in-dubai/)** in sexual health discussions promotes awareness and reduces stigma around less commonly discussed infections.
# Choosing the Right Test for Your Needs:
Selecting the right STI test depends on symptoms, risk factors, and sexual activity. While standard STI panels are a good starting point, they may not provide a complete picture. Asking about Trichomoniasis testing ensures more comprehensive screening and peace of mind.
Healthcare providers can recommend appropriate tests based on individual circumstances, helping tailor care to specific needs.
# Final Perspective on Trichomoniasis Testing Differences:
A Trichomoniasis test stands apart from other STI tests due to the nature of the infection and how it is detected. Its parasitic cause, inconsistent symptoms, and exclusion from routine screening make targeted testing essential.
Understanding these differences empowers individuals to take a proactive approach to sexual health. Comprehensive testing, informed decision-making, and preventive practices work together to reduce risk and support long-term well-being.